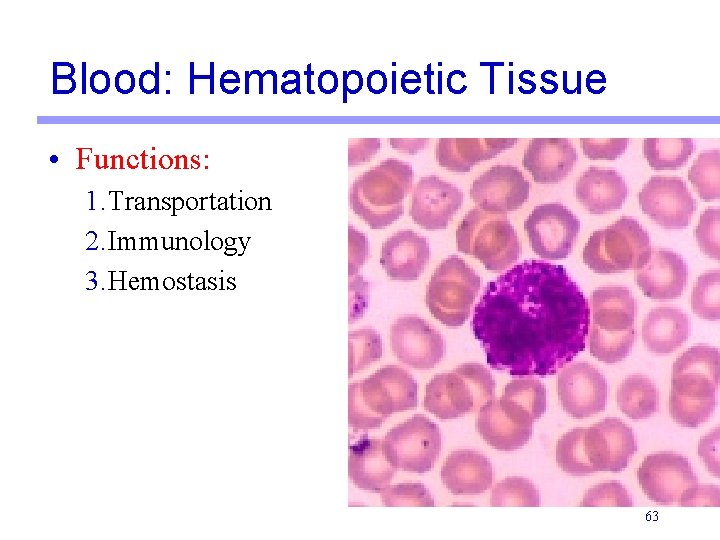

Lab Exercise 5 Epithelial and Connective Tissues Portland

Lab Exercise 5 Epithelial and Connective Tissues Portland Community College BI 231

Tissues • Groups of cells similar in structure and function • Each tissue is then further subdivided into categories. • All organs are made of a combination of different tissues. • The four types of tissues • • Epithelial Connective Muscle Nerve 2

Epithelium • Covers all body surfaces, inside and out • Is anchored to connective tissue by a layer of glycoproteins and protein fibers called the basal lamina 3

Epithelial Tissue Distinguishing Characteristics 1. Cellularity: Composed almost entirely of cells 2. Polarity: apical and basal surfaces (top and a bottom) 3. Attachment: Supported by connective tissue (basement membrane) 4. Avascular: Contains no blood vessels: obtains nutrients by diffusion 5. Regeneration: Rapidly replaces lost cells by cell division 4

Functions of Epithelia • • • Protection: Secretion: Absorption: Sensory: Filtration: Skin glands release secretions Uptake nutrients Taste buds In the kidneys 5

Classification of Epithelia 1. First name: • • Simple: one layer Stratified: more than one layer 2. Second name: • Based on the shape of the top layer of cells • Squamous (flat) • Cuboidal (square) • Columnar (rectangle) 3. Two additional categories • • Transitional Pseudostratified 6

Classification of Epithelia 7

Classification of Epithelia • Squamous • Cuboidal • Columnar 8

Simple Squamous Epithelium • Single layer of flattened cells with discshaped nuclei and sparse cytoplasm 9

Simple Squamous Epithelium • Top View 10

11

Simple Squamous Epithelium 12

Simple Squamous Epithelium • Functions: 1. Diffusion • Alveoli in the respiratory system allows for exchange of O 2 and CO 2 2. Filtration • Capillaries allow fluid and other substances out and holds blood cells and proteins in 3. Lubrication • Secretes lubricating substances in serosae 13

Simple Cuboidal Epithelium • Single layer of cube like cells with large, spherical central nuclei 14

15

Simple Cuboidal Epithelium 16

Simple Cuboidal Epithelium • Functions: 1. Secretion • Glands such as the thyroid are composed of simple cuboidal epithelium and secrete hormones ect… 2. Absorption • In the kidney, the proximal convoluted tubule is composed of simple cuboidal epithelium and reabsorbs water and other nutrients from the filtered fluid 17

Simple Columnar Epithelium • Single layer of tall cells with oval nuclei toward the basal surface • Goblet cells are often found in this layer 18

Simple Columnar Epithelium 19

Simple Columnar Epithelium 20

Simple Columnar Epithelium • Functions 1. Secretion • Example: In the stomach, these cells secrete digestive enzymes 2. Absorption • Example: In the intestine, these cells absorb nutrients 21

Stratified Squamous Epithelium • Composed of several layers of cells • Top layer flat • Bottom layers any shape • Function in protection of underlying areas subjected to abrasion 22

Stratified Squamous Epithelium • Non-keratinized • Composed of several layers of cells • Top layer flat • Bottom layers any shape 23

Stratified Squamous Epithelium Non-Keratinized 24

Stratified Squamous Epithelium Non-Keratinized • Functions 1. Physical protection against abrasion and pathogens • Non-Keratinized is associated with “moist” areas • Mouth • Throat • Esophagus • Anus • Vagina 25

Stratified Squamous Epithelium Keratinized Looks “flakey” on the top 26

Stratified Squamous Epithelium Keratinized 27

Stratified Squamous Epithelium Keratinized • Functions 1. Physical Protection • Found only in the epidermis of the skin • Keratin is a protein that helps strengthen the cells against abrasion 28

Pseudostratified Columnar Epithelium • Single layer of cells with different heights; some do not reach the free surface • Nuclei are seen at different levels • May be ciliated (PCCE) or non-ciliated 29

Pseudostratified Columnar Epithelium 30

Pseudostratified Columnar Ciliated Epithelium (PCCE) 31

Pseudostratified Columnar Ciliated Epithelium (PCCE) • Functions 1. Protection • Example: Lines the upper respiratory tract. The cilia sweep debris toward the throat 2. Secretion • Example: May contain goblet cells (unicellular glands) that secrete mucus 32

Transitional Epithelium • • Several cell layers, basal cells are cuboidal Apical cells are dome shaped when not stretched • Apical cells are flat when stretched • Only found in Urinary System • Functions: 1. Allows expansion and recoil after stretching 33

Transitional Epithelium Distended bladder Empty bladder 34

Stratified Cuboidal and Columnar • • Typically two cell layers thick Rare • Functions: 1. Secretion • Found in some sweat and mammary glands 35

Stratified Cuboidal Epithelium 36

Stratified Cuboidal Epithelium 37

Stratified Columnar Epithelium • • • Limited distribution in the body To tell the difference between this and pseudostratified columnar, look at the nucleus. • The nuclei are lined up in a straight row Function 1. Protection • Found in the pharynx, male urethra, lining some glandular ducts, and anus 38

Stratified Columnar Epithelium 39

Stratified Columnar Epithelium 40

Connective Tissue • 4 Types 1. Connective Tissue Proper 2. Bone 3. Blood 4. Cartilage 41

Connective Tissue Features 1. Specialized cells 2. Matrix: Nonliving material between the cells that makes up most of the volume (ground substance + fibers) • Extracellular fibers • Ground substance: Composed chiefly of interstitial fluid, cell adhesion proteins, and proteoglycans • Specific composition varies between tissues (Blood=fluid, Cartilage=gel like, Bone=Solid) 42

Connective Tissue Fibers • 3 types of fibers include collagen, elastic and reticular • Collagen Fibers: Fibrous protein molecules • Extremely tough • High tensile strength • Strongest type of fibers in connective tissue. 43

Connective Tissue Fibers • Elastic Fibers: Form branching networks • Elastin: a rubber like protein that allow it to act like a rubber band snap back to its original shape after it is stretched • Reticular Fibers: Forming delicate networks • Fine collagenous fibers (with a different chemical structure) branch extensively • Surround small blood vessels and support soft tissue organs 44

Blast cells • Undifferentiated cells (blast = forming) • Fibroblasts- fount in loose and dense connective tissues (secrete matrix) • Chondroblasts in cartilage • Osteoblasts in bone • Hemocytoblasts in blood • ‘cytes’ are the mature forms 45

Cells of Connective Tissue Proper 1. Reticular cells: specialized fibroblasts found in reticular connective tissue 2. Macrophages: Scavenger cells that engulf pathogens or damaged cells 3. Adipocytes: Fat cells 4. Plasma cells: produce antibodies 5. Mast cells: Stimulate local inflammation: contain histamine and heparin 6. Leukocytes: WBC involved in immunity 46

Mesenchyme • Embryonic Connective tissue • Gel-like ground substance with fine protein fibers and immature cells; gives rise to all other connective tissues 47

Areolar Connective Tissue (Loose) • • • Gel like matrix Contains all 3 fiber types Functions: 1. Wraps and cushions organs 2. Holds and conveys tissue fluid • Locations: 1. Under epithelial tissues 2. Packages organs 3. Surrounds capillaries 48

Areolar Connective Tissue (Loose) Fibroblast Collagen fiber Macrophage Elastic fiber 49

Adipose Tissue (Loose) • Function: 1. Storage of lipid molecules 2. Insulation 50

Reticular Connective Tissue (Loose) • • Network of reticular fibers in a loose ground substance Functions 1. Soft internal skeleton that supports other cell types • Locations 1. Lymph nodes 2. Bone marrow 3. Spleen 51

Reticular Connective Tissue (Loose) 52

Dense Regular Connective Tissue • Primarily parallel collagen fibers • Major cell type: fibroblast • Functions: 1. Withstands great tensile stress pulling in one direction • Locations: 1. Tendons 2. Ligaments 3. Aponeuroses 53

Dense Regular Connective Tissue 54

Dense Irregular Connective Tissue • • Irregularly arranged collagen fibers Functions: 1. Withstands tension exerted in many directions 2. Provides structural strength • Locations: 1. Dermis of skin 2. Submucosa of digestive tract 3. Fibrous capsules of organs and joints 55

Dense Irregular Connective Tissue 56

Elastic Connective Tissue (Dense) • • Dense regular CT dominated by elastic fibers Functions: 1. Stabilizes positions of vertebrae and penis 2. Cushions and permits expansion and contraction of organs • Locations: 1. Between vertebrae 2. Ligaments supporting penis, transitional epithelia 3. Blood vessel walls 57

Elastic Connective Tissue (Dense) 58

Hyaline Cartilage • Functions: 1. Stiff but flexible support 2. Reduces friction between bony surfaces • Locations: 1. Articular surfaces 2. Larynx 3. Trachea 4. Nasal septum 59

Elastic Cartilage • Functions: 1. Support, but flexible • Locations: 1. Ear 2. Epiglottis 60

Fibrocartilage • Functions: 1. Resists compression 2. Prevents bone-tobone contact • Locations: 1. Meniscus of knee 2. Pubic symphysis 3. Intervertebral discs 61

Bone: Osseous Tissue • Functions: 1. Lever for muscles 2. Mineral storage 3. Protection 62
Blood: Hematopoietic Tissue • Functions: 1. Transportation 2. Immunology 3. Hemostasis 63

The End 64
- Slides: 64